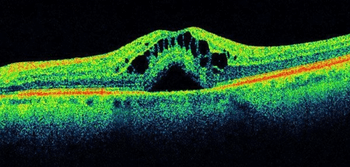

Retina specialists Caesar Luo, MD, of Bay Area Retina Associates (Walnut Creek, CA) and S.K. Steven Houston III, MD, of Florida Retina Institute, share their outlooks on retina innovation in the "year of the eye" amid a global pandemic.

Retina specialists Caesar Luo, MD, of Bay Area Retina Associates (Walnut Creek, CA) and S.K. Steven Houston III, MD, of Florida Retina Institute, share their outlooks on retina innovation in the "year of the eye" amid a global pandemic.

Dilraj Grewal, MD, speaks on his presentation "Evaluating the True 3-Year Recurrence Rate in Non-infectious Posterior Segment Uveitis Following an Injectable Fluocinolone Acetonide Insert," during ASRS 2020.

This action will result in 2 separate companies,

Intravitreal injection offers safety, efficacy, and improved vision in patients

Justis P. Ehlers, MD, speaks on the key findings and take-aways from his presentation "Impact of baseline OCT characteristics on response to risuteganib for the treatment of intermediate age-related macular degeneration (AMD)."

Daniel F. Kiernan, MD, FACS, speaks on the key findings and take-aways of his presentation "Dexamethasone intracameral drug-delivery suspension for inflammation associated with vitreoretinal surgery."

S.K. Steven Houston III, MD, discusses retina innovations in use in his practice, including the NGENUITY 1.4 upgrade from Alcon, and adapting to ever-changing operating room spacing and set-up in the COVID-19 environment

Caesar Luo, MD, shares the take-away points from his ASRS presentation, and how the topics from his talk may be applied day to day in retinal practice.

Theresa Heah, MD, provides an update on AsclepiX’s AXT107, which is derived from a cryptic peptide within collagen IV that works by activating naturally existing, homeostatic mechanisms of angiogenesis.

How gonioscopy can offer ophthalmologists an option in treating patients with glaucoma

ASRS 2020: Josh Anderson speaks on the highlights from Alcon, including new data on the performance benefits of the Hypervit dual blade 20,000 cpm probe and the launch of the NGENUITY 1.4 upgrade.

Derek Kunimoto, MD, JD, focuses on Aviceda's technology, which will aim to target various immune system responses that contribute to pathology associated with dry AMD.

Researchers must weigh emotional, financial, and reputational considerations

ASRS 2020 coverage: Peter Campochiaro, MD, detailed findings of phase 2 of the Ladder Trial and ongoing Archway Trial during the virtual 2020 American Society of Retina Specialists (ASRS) annual meeting.

ASRS 2020 coverage: The results of the Protocol T Extension Study underscore the need for methods to improve long-term visual gains in eyes with diabetic macular edema, according to Dante Pieramici, MD,on behalf of the DRCR Retina Network.

Trabeculectomy may offer better results with more severe glaucoma

ASRS 2020 coverage: Carl Danzig, MD, presented results of phase 2 Stairway Trial during the virtual 2020 American Society of Retina Specialists (ASRS) annual meeting. Faricimab is a bispecific antibody that simultaneously inhibits angiopoietin-2 and vascular endothelial growth factor A.

Technology is off to a good start, but improvements still needed

ASRS 2020 coverage: An augmented-reality device provides AMD patients with enhanced reading ability and facial recognition.

ASRS 2020 coverage: Intravitreal liposome-encapsulated bromfenac is under study as a treatment for refractory DME. Results of a pilot study were detailed at the virtual 2020 American Society of Retina Specialists (ASRS) annual meeting.
ASRS 2020 coverage: The Audacious Goals Initiative of the National Eye Institute is focused on developing noninvasive imaging advances to help patients with vision loss.

Diagnostic and monitoring advances in glaucoma need fine-tuning

With an eye on innovation, money is driving research of new therapies and devices.

Industry develops creative approaches to help increase patient medication adherence

One company is providing urgent eye care to patients in a refugee camp settlement of Rohingya.

Panel discusses IOP monitoring, drug delivery, data collection

For many physicians, “moral injury” may be actual issue

High-level observations for how the latest developments can help glaucoma specialists solve problems to achieve the utmost in patient care

Besides traditional medications, here are some of the many novel approaches to treat patients with glaucoma

There are other mimickers of NTG that should be kept in mind